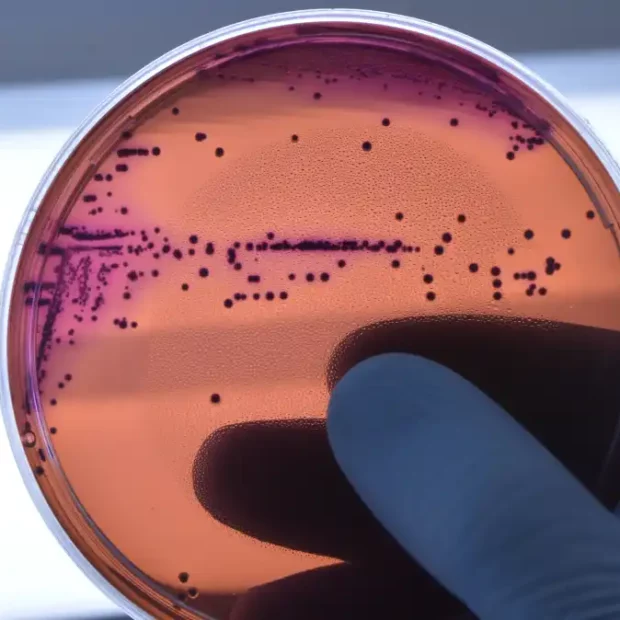

Uma a cada seis infecções bacterianas foi resistente a tratamentos com antibióticos, de acordo com os dados mais recentes do Sistema Global de Vigilância da Resistência e do Uso de Antimicrobianos (Glass) divulgado nesta segunda-feira, 13, pela Organização Mundial da Saúde (OMS). Entre 2018 e 2023, mais de 40% das combinações entre patógenos e antibióticos monitoradas apresentaram um aumento na resistência. Nesse período, o crescimento médio anual da resistência variou entre 5% e 15%.
“A resistência antimicrobiana está avançando mais rápido que os progressos da medicina moderna, ameaçando a saúde das famílias em todo o mundo”, citou Tedros Adhanom Ghebreyesus, diretor-geral da OMS, em comunicado à imprensa.
“À medida que os países fortalecem seus sistemas de vigilância da RAM (resistência antimicrobiana), devemos usar os antibióticos de forma responsável e garantir que todos tenham acesso aos medicamentos adequados, a diagnósticos de qualidade e a vacinas. Nosso futuro também depende do fortalecimento dos sistemas de prevenção, diagnóstico e tratamento de infecções, além da inovação em antibióticos de nova geração e testes moleculares rápidos”, acrescentou.
A OMS estima que a resistência a antibióticos é mais prevalente nas regiões do Sudeste Asiático e do Mediterrâneo Oriental, onde uma em cada três infecções relatadas era resistente. Na região africana, uma em cada cinco infecções mostrou resistência aos antibióticos. Esse problema, segundo a organização, é mais frequente e vem se agravando em países onde os sistemas de saúde têm pouca estrutura para identificar ou tratar infecções causadas pelas bactérias.
Bactérias gram-negativas
Segundo o relatório, as bactérias conhecidas como gram-negativas, como E. coli e Klebsiella pneumoniae, representam a principal ameaça. Elas estão entre as principais responsáveis por infecções na corrente sanguínea, que podem causar sepse, falência de órgãos e até a morte. Atualmente, mais de 40% das cepas de E. coli e mais de 55% das de K. pneumoniae no mundo são resistentes às cefalosporinas de terceira geração, ou seja, o tratamento de primeira escolha para essas infecções. Na região africana, a resistência passa dos 70%.
Além disso, outros antibióticos muito usados, como os carbapenêmicos e as fluoroquinolonas, perderam eficácia contra E coli, Klebsiella pneumoniae, Salmonella spp. e Acinetobacter spp. Essa situação reduziu as opções de tratamento e obriga o uso de antibióticos de último recurso, que são caros, difíceis de obter e muitas vezes indisponíveis em países de baixa e média renda.
No Brasil, o principal risco são as infecções da corrente sanguínea. O patógeno mais prevalente foi o Staphylococcus aureus, respondendo por 36,9% dos casos, com mais da metade deles (52,8%) sendo resistente à meticilina. A Klebsiella pneumoniae e a Escherichia coli também apareceram com frequência, representando 25,5% e 25,9% dos casos, respectivamente. Entre elas, a K. pneumoniae apresentou 41,1% de resistência ao antibiótico de reserva imipenem, e a E. coli mostrou 34,6% de resistência às cefalosporinas de terceira geração, que são usadas como antibióticos de vigilância.
Nas infecções do trato urinário, a E. coli teve alta resistência aos antibióticos de primeira linha, como o cotrimoxazol (46,8%), e também apresentou resistência significativa aos antibióticos de vigilância, incluindo fluoroquinolonas (37,5%) e cefalosporinas de terceira geração (25,8%).
Reforço da vigilância
O estudo avaliou dados de 104 países e acompanhou a indicação de 22 antibióticos no tratamento de infecções urinárias, intestinais, na corrente sanguínea, além de gonorreia. Também analisou oito tipos de bactérias comuns, entre elas E. coli, Klebsiella pneumoniae e Staphylococcus aureus, que estão associadas a esses tipos de infecção.
A OMS reforça que mais países precisam reforçar a vigilância antimicrobiana. De acordo com a entidade, a participação dos países no Glass aumentou mais de quatro vezes, passando de 25 nações, em 2016, para 104, em 2023. No entanto, 48% dos países não enviaram dados ao sistema em 2023, e cerca de metade dos que relataram ainda não possuíam sistemas capazes de gerar dados confiáveis. Na verdade, aponta a OMS, os países que enfrentam os maiores desafios careciam da capacidade de vigilância necessária para avaliar sua situação de resistência aos antimicrobianos.
Por isso, a organização reforça a importância da participação dos países no estudo até 2030. Em 2024, a Assembleia Geral da Organização das Nações Unidas (ONU) adotou uma declaração política sobre resistência antimicrobiana, estabelecendo metas para fortalecer os sistemas de saúde e promover uma abordagem de saúde única, que integra ações nos setores de saúde humana, animal e ambiental.
Estadão Conteúdo